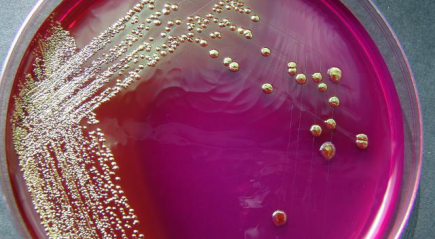
Escherichia coli Escherichia coli

Esherichia coli в мазке
Esherichia coli или кишечная палочка является нормальным обитателем желудочно-кишечного тракта человека. Она не только проявляется антагонистическую активность в отношении гнилостной микрофлоры, но и участвует в синтезе витаминов группы В. Однако данный микроорганизм может становиться весьма опасным при выходе за пределы кишечника. В этом случае кишечная палочка вызывает опасные и подчас трудно поддающиеся лечению заболевания.
Диагностировать инфекцию, вызванную Esherichia coli, можно с помощью обыкновенного мазка. Так бактерия может выделяться при исследовании флоры половых путей. В данном случае можно предположить, что именно кишечная палочка стала причиной кольпита, цервицита, эндометрита, аднексита или других воспалительных процессов в полости малого таза у женщин.
Обнаружить кишечную палочку можно и в мазке из уретры. Чаще всего это случается при обследовании женщин, анатомические особенности строения половых органов которых создают благоприятные условия для распространения инфекции из прямой кишки на область промежности. При этом женщина может страдать от цистита, так как именно Esherichia coli является наиболее частым его возбудителем. У мужчин же выявление кишечной палочки в мазке из уретры может свидетельствовать не только о наличии цистита, но и развитии уретрита, простатита.
Признаки жизнедеятельности кишечной палочки могут быть обнаружены и в ротовой полости. Обычно это выявляется при исследовании мазка с поверхности миндалин. У пациентов с такими изменениями в анализах нередко наблюдаются тяжелые, склонные к рецидивированию ангины.
Однако Esherichia coli может приводить к развитию патологического состояния и в месте своего естественного обитания – кишечнике. Данное заболевание называется кишечным дисбактериозом и заключается в нарушении баланса между содержанием кишечной палочки и других бактерий в просвете кишечника. Это может произойти, например, при заражении особенно агрессивными штаммами бактерии при употреблении недоброкачественных продуктов. Признаки дисбактериоза могут быть выявлены в мазке из анального канала.
Несомненно, выявление Esherichia coli в мазке чаще всего является поводом для проведения активного лечения. В основе терапии инфекций, вызванных кишечной палочкой, лежит использование различных групп антибиотиков. После проведения курса антибактериального лечения желательно применять про- и пребиотики, способствующие восстановлению микрофлоры.













Добавить комментарий